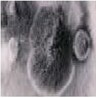

中央空调系统、室内污染现状
当建筑物内空气被流行性致病菌感染,而空调又得不到及时有效的消毒时,病菌就会通过中央空调“散布”,经呼吸道传播的疾病是一个隐形的过程,往往使人无法觉察,加之人们不能用肉眼直观判断空调风的洁净程度,所以极易被忽视。
中央空调系统中恒温,恒湿的环境为微生物的繁殖提供了良好的培养基,根据中央空调系统工作原理,空气在流通过程中都要经过风管,而一旦风管或风口受到污染,病毒、细菌等微生物就可以通过管道在整个空间内循环。当空调系统内细菌达到一定数量时,细菌将侵袭抵抗力弱的人,使其患上疾病。
现代楼宇空气污染
1、许多办公环境中电脑等现代化办公设备众多,产生电磁辐射和电离辐射,造成空气污染物的 复杂化学反应,进而产生大量的有机污染物。
2、写字楼为了降低空调能耗,一方面提高建筑物的气密性和绝缘性,同时又在降低室内最小新风量标准,并采用内循环模式,使污染的空气被回风系统吸回风管系统后再次排出,浓缩了污染物,让室内空气污染比室外严重5~10倍。
3、公共场所人群拥挤、空气浑浊,细菌病毒等治病因子极易传播。
4、公共场所空调新风量难达标,集中空调的交叉感染性给传播性病菌提供了良好条件。
现代医院空气隐患
1、候诊大厅:候诊大厅为人员最为密集,病员最为复杂的公共场所。尤其是传染性疾病,很容易在此场所中传播,造成交叉感染。
2、VIP病房:现代医院往往采用玻璃幕墙的建筑形式,由于建筑自身的密闭性,在获得了建筑美观的同时也“牺牲”了室内人员的健康。
3、ICU病房:重症监护病人一般病情较为严重,自身抵抗力及机能力极度下降。急诊输液室:急诊输液室大部分都是急重症病人,情况相对比较复杂,共同特点是抵抗力低、细菌病毒的感染几率大,急诊输液室药品和人体自身的异味比较严重。
4、手术室:敏盛空气净化系统在手术室中起到的作用是综合性的,主要作用有杀灭空气中、集中空调系统中浮游菌、病毒、微生物,降低感染率;消除手术过程中人体及其药剂释放出的异味;消除手术设备所产生的大量静电和臭氧,保护精密仪器及设备;在层流手术室中,还可以通过负氧离子对超粒子的凝聚效应,进一步提高空气过滤效率;及时补充空气中氧离子数量,消除疲劳,提高工作效率,沉降手术室的可吸入颗粒物。
|
医院集中空调系统及室内主要污染物
|
|
 |
细菌病毒
迄今为止,已知的能引起呼吸道病毒感染的病毒就有 200 种之多,包括目前正在传播的非典病毒,这些感染的发生绝大部分是在室内通过空气传播的,其症状可从隐性感染直到威胁生命。
|
 |
流行性感冒(甲流 H1N1)
中国卫生部明确将甲型 H1N1 流感(原称人感染猪流感)纳入传染病防治法规定管理的甲类传染病,并采取甲类传染病的预防、控制措施。
|
 |
传染性非典型肺炎(SARS)
SARS(非典型性肺炎)病毒一度是公众关注的焦点,净化空气,预防传染成了公共卫生的主题。纳米光子空气净化器细菌、病毒的杀灭率可达到 99.9%。
|
 |
军团菌病
“军团菌病”是一种以肺炎为主的急性呼吸系统传染病,表现为高烧、寒颤、咳嗽、胸痛、呼吸困难和腹泻等,一旦暴发流行对人群危害极大,集中空调系统是军团菌的理想的居住和繁殖场所。
|
|
霉菌
霉菌是一种能够在温暖和潮湿环境中迅速系列的微生物,其中一些能够引起恶心、呕吐、腹痛等症状,严重的会导致呼吸道及肠道疾病,如哮喘、痢疾等。
|
 |
尘螨
尘螨是最常见的空气微小生物之一,是一种很小的节肢动物,肉眼是不易发现的。尘螨是引起过敏性疾病和罪魁祸首之一,室内空气中尘螨的数量与室内的温度、湿度和清洁程度相关。
|
|
其它污染物
|
各类病人所带来的病毒、空气中可吸入颗粒物、VOC等总挥发性有机物等。
|
高能纳米光氢离子中央空调空气消毒净化器简介
中央空调纳米技术是采用德国先进的空气纳米分解技术,该技术是一种仿生态的高级空气氧化技术,通过双波长宽波幅高能光子管发出的特定线长的能量光波照射多种稀有金属催化材料,利用高温烧结工艺制成的贵金属纳米催化层的亲水性,产生过氧化氢、羟基自由基、超氧离子及纯态负离子等高级氧化性粒子,光催化活性产生的光氢离子团被激活、电离、裂解,能够在瞬间杀死过风空气当中的大量细菌、微生物、病毒,灭菌效能达到99%以上,并起到降尘作用,保证室内空气的洁净与安全。此技术已通过多项环保认证并广泛使用。
高能纳米光氢离子净化原理说明
光催化原理图

高能纳米光催化技术的原理是利用紫外线C波段,照射在贵金属纳米光催化部件上,对空气中的氧分子进行电离、碰撞、结合,通过光电化学产生出过氧化氢、羟自由基及负离子。过氧化氢以及羟自由基均有较强的氧化还原作用,杀菌消毒并降解VOC。
光子波技术特点
光子波的特定光波频率介于不可见光和紫外线波长之间,空气中的氧气和水蒸气受到特定的频谱的光波的照射后,产生光电化学反应,生成臭氧、过氧化氢、羟自由基及负离子。
氢氧自由基
纳米光子波与空气中的水接触时,表面就吸附H2O,O2 和OHˉ。而H2O 和OHˉ被空穴(h+)所氧化,O2被电子(e-)还原,反应式如下:
H2O+h+ —— OH+H+
O2+e- —— O2
OHˉ基团的氧化能力较强,使有机物迅速氧化。不但对不可见光具有很好的吸收能力,同时对可见光也有较高的吸收能力;它激发电子到达表面时间快,并且使生长电子、空穴不易复合,具有较高的光催化反应活性;比表面积大,吸收能力强,可与污染物(臭气)更充分地接触。
羟自由基
羟自由基也是极强的氧化剂,能迅速杀灭病毒、细菌、真菌等微生物(千分之一秒)。
负离子
负离子可以沉降空气中的灰尘、花粉、烟尘等污染物,形成大颗粒落下,从而净化了空气。
纳米镀层
光子发光管或净化器内壁上还有一层纳米级高科技复合材料的镀层。应用纳米高科技复合材料的镀层是一种禁带宽度很大的材料,当吸收表面辐射光子波时,纳米镀层价带上的电子被激发越过禁带进入导带。在价带上产生相应的空穴(h+),同时也生成电子(e-),此时 e-与h+分离,将吸收的光能转换为化学能即具有光催化作用。这种纳米光子波纯正而没有二次污染,不会产生人们不愿意看到的氮氧化合物这一有害气体。
高能纳米光氢离子技术七大优势
1.快速
高能纳米光氢离子洁净技术的净化效率比臭氧高300 倍,比紫外线高4000 倍。净化离子系统能在飞沫起始传播的2 米内,杀灭其中90%的病菌,大大降低了疾病通过空气传播的可能性,对于流感病毒也有很好的杀菌效果。
2.全面
高能纳米净化技术可全面消除细菌、霉菌、病毒等有害微生物,分解有毒气体、去味除烟,沉降小至0.01微米的颗粒物。
3.主动
多数空气净化设备只是利用循环处理的方式,对空气进行了“被动处理”,速度慢效果差,容易出现卫生死角。高能纳米技术产生净化粒子遍布于整个空间中,主动分解各种有害污染物,并且可以同时杀灭细菌病毒,预防空气传播疾病。
4.完全
可以在人居环境下长期使用而不对人体造成任何伤害。
5.经济
过滤式空气净化装置需要频繁更换过滤装置和定期维护,成本较高。采用高能纳米技术的空气净化器一次性投入,无需配件,使用寿命长达15年。
6.方便
采用轻巧化设计, 产品体积小重量轻,便于安装与拆卸、使用无需专人维护。
7.静音
无运转部件,不会产生任何额外噪音。
产品选型表
|
产品型号
|
规格(mm)
|
处理风量(m3/h)
|
电压(V)
|
功率(W)
|
|
CL-1
|
192*165*140
|
2000以下
|
220
|
定制
|
|
CL-2
|
192*165*140
|
2000~4000
|
220
|
定制
|
|
CL-3
|
192*165*140
|
4000~10000
|
220
|
定制
|
|
CL-4
|
定制
|
10000~20000
|
220
|
定制
|
|
CL-5
|
定制
|
20000~30000
|
220
|
定制
|
|
CL-6
|
定制
|
30000~40000
|
220
|
定制
|
|
CL-7
|
定制
|
40000~50000
|
220
|
定制
|
|
……
|
|
|
|
|
产品安装图示

净化技术指标:
空气消毒洁净器 ——符合:<卫生部 医院消毒技术规范>
可动态连续消毒对人体无害——符合:<卫生部 医院消毒技术规范>
可处理风量:200 风量~不限m3/h——适合:单间房屋或管道中央空调/风机盘管
装置阻力:≤15Pa ——符合:<公共场所集中空调通风系统卫生规范>
消毒效果一次通过除菌率≥99%—符合:<公共场所集中空调通风系统卫生规范>
微生物净化效率:一次通过≥90%——符合:<公共场所集中空调通风系统卫生规范>
细菌总数≤500cfu/m3—— 符合:<公共场所集中空调通风系统卫生规范>
真菌总数≤500 cfu/m3——符合:<公共场所集中空调通风系统卫生规范>
臭氧浓度≤0.10 mg/m3——符合GB/T 18883 室内空气质量标准
连续运行效果:效率下降<10% ——符合:<公共场所集中空调通风系统卫生规范>
负离子产生器产生1*106 负离子/cm3
注:可方便安装在组合式空调箱、送回风总管以及送回风口上